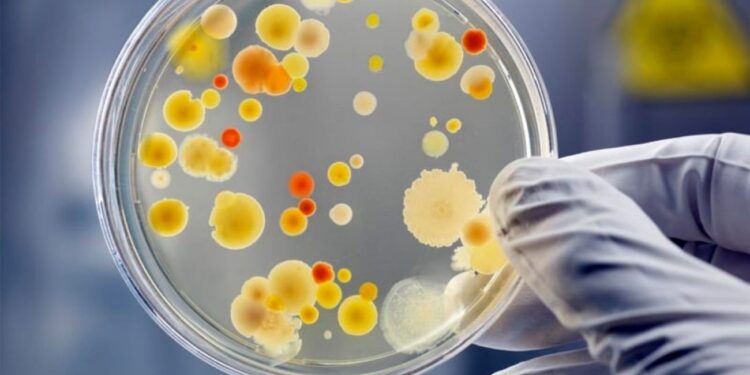
გამოვლინდა ბოტულიზმის შემთხვევა! -სურსათის ეროვნული სააგენტო მოსახლეობას აფრთხილებს

შიდა ქართლში საკვებისმიერი ბოტულიზმის შემთხვევა გამოვლინდა!
ამის შესახებ ინფორმაციას სურსათის ეროვნული სააგენტო ავრცელებს.
უწყება მოქალაქეებს აფრთხილებს, რომ საეჭვო პირობებში დამზადებული შებოლილი ხორცის, თევზის, ასევე დაკონსერვებული სურსათის მოხმარებისაგან თავი შეიკავონ.